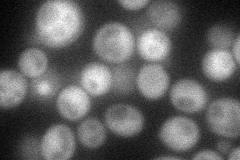
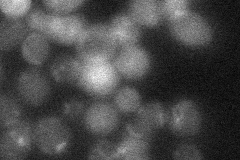

View description
Transcription factor (bHLH) involved in interorganelle communication between mitochondria, peroxisomes, and nucleus
Localization:
Intensity:
Fold change:
Significance:
-
C’ GFP library in SD

nucleus:cytosol24.71 -
N' NOP1pr-GFP in SD
cytosol,punctate55.3483 -
N' TEF2pr-mCherry in SD

cytosol62.9547 -
N' NATIVEpr-GFP in SD
cytosol21.6051 -
N' TEF2pr-VC and Cyto-VN in SD

cytosol32.7724 -
C’ GFP library in SD+DTT

nucleus.cytosol17.660.71Yes -
C’ GFP library in SD+H2O2

nucleus.cytosol25.021.01No -
C’ GFP library in Starvation Media

nucleus,cytosol19.740.79No -
C’ GFP library on the background of Pup2-DaMP

nucleus:cytosol -
C’ GFP library on the background of CCT mutant

nucleus:cytosol22.58940.913922No
